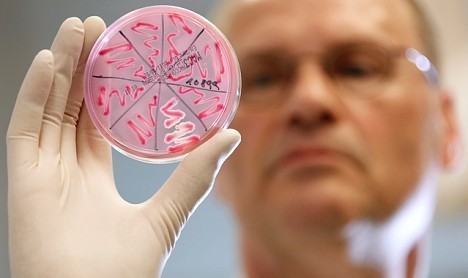

Боишься простуды? Закаливайся!

Существует большая группа заболеваний, которая хотя и не является причиной частой инвалидности и смерти, как сердечно-сосудистая патология, но тем не менее занимает первое место среди заболеваемости населения и связанных с нею трудопотерь. Речь идет о простудных…
Об онкологических заболеваниях
Онкологические заболевания — одни из самых коварных. Сегодня о методах их профилактики мы беседуем с доктором медицинских наук за — местителем главного врача по хирургии краевого онкологического диспансера Гамлетом Арутюняном. — Гамлет Арменакович, известно, что причин, вызывающих…
Лечим сосуды: артерии, капилляры, вены

Артерии, капилляры, вены, замкнутые, словно ожерелье, рубином сердца… Как поддерживать работу этой сложной системы в хорошей форме? По сосудам-артериям алая артериальная кровь доставляет каждой клеточке тела кислород, питательные и строительные вещества. А по сосудам-венам темная венозная кровь…

У каждой второй женщины и каждого четвертого мужчины проблемы с венами ног. Требуется постоянное и упорное лечение, которое на ранних стадиях заболевания достигается простыми и доступными, но эффективными средствами. Почему ноги страдают при заболевании вен…

Почка вырабатывает особое вещество ренин, из которого потом образуется фермент ангеозин. Он сужает мелкие сосуды, вследствие чего почка заболевает, и возникает гипертония. При значительном повышении артериального давления почка страдает не меньше, чем от воспалительного процесса…
Острая кишечная инфекция - причины, симптомы, лечение, профилактика
Источниками острой кишечной инфекции являются больные различной тяжести в остром периоде болезни, но наиболее опасными в эпидемиологическом смысле являются больные легкими, стертыми формами заболевания и бактерионосители. Последние, как правило, не обращаются за медицинской помощью…
Массаж шиацу при болях в животе, простуде, насморке, хрипоте

В наши дни, когда мы находимся под опекой медицины, древний восточный метод может играть вспомогательную роль при лечении некоторых заболеваний. Самостоятельное значение он приобретает, как это и было много веков, если врачебная помощь отсутствует. Боли в животе. Часто они сопутствуют гастриту…

Глюкометр — специальный электронный прибор, который позволяет измерять уровень глюкозы (сахара) в крови в домашних условиях, в дороге, при физических нагрузках — везде. Современный подход в лечении сахарного диабета предполагает, что больной знаком с основами самоконтроля — это постоянное, частое…
Уретрит - причины, симптомы, лечение

Уретрит — это воспаление мочеиспускательного канала — уретры. Заболевание проявляется резями, жжением, зудом в мочеиспускательном канале. Мочеиспускание может быть затрудненным, учащенным. Вы, наверное, знаете, какие ощущения бывают при ожоге…
Причны, симптомы, предупреждение, профилактика, лечение дисбактериоза

Дисбактериоз (или дисбиоз) — это качественное или количественное нарушение микрофлоры в желудочно-кишечном тракте. Нормальная флора кишечника представлена преимущественно бифидофлорой, лактобактериями и кишечной палочкой. Эти бактерии нормализуют работу кишечника, участвуют в синтезе некоторых витаминов…

Вирус папилломы человека — (ВПЧ) — это небольшие бугорки (кондиломы или бородавки на тонкой ножке), появляющиеся на пенисе, в области анального отверстия и на мошонке (у женщин они также локализуются в аногенитальной области). Они настолько малы, что некоторые из них трудно увидеть…
Практика применения витамина С для лечения рака

Витамин С — аскорбиновая кислота, или аскорбат натрия или кальция, — участвует в большинстве биохимических процессов в организме. Две важнейшие «статьи расхода» витамина С заключаются в укреплении иммунной…
Факторы риска возникновения желчнокаменной болезни

К факторам риска возникновения желчнокаменной болезни относятся: — возрастной фактор и наследственность (у тех, кто имеет это заболевание в роду, риск образования желчных камней повышается в 2-4 раза); — частые беременности и роды; — несбалансированное или однообразное питание; — ожирение с нарушением…

В Канаде было зарегистрировано около 51000 новых случаев рака кожи, из них 47000 случаев базальноклеточного и плоскоклеточного рака (БКР и ПКР), которые обычно относят к немеланомному раку (НМР) кожи. Данные опухоли редко метастазируют и обычно легко поддаются лечению…
В настоящее время под атеротромбозом понимается внезапный разрыв или наличие трещины на поверхности атеросклеротической бляшки. Клинически это может проявляться инсультом, стенокардией, брюшной жабой, поражениями в артериях нижних конечностей и т. д. Атеротромбоз — заболевание генерализованное…
